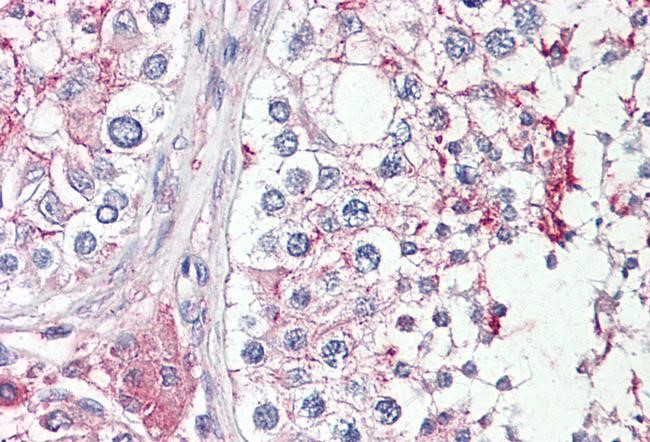

HRASLS1 / HRASLS Antibody
LS-C816526
ApplicationsImmunoHistoChemistry, ImmunoHistoChemistry Paraffin
Product group Antibodies
TargetPLAAT1
Overview
- SupplierLifeSpan BioSciences
- Product NameHRASLS1 / HRASLS Antibody
- Delivery Days Customer14
- Application Supplier NoteApplications should be user optimized.
- ApplicationsImmunoHistoChemistry, ImmunoHistoChemistry Paraffin
- Applications SupplierIHC-P (1:50 - 1:200) Applications should be user optimized.
- CertificationResearch Use Only
- ClonalityPolyclonal
- ConjugateUnconjugated
- Estimated Purity...
- Gene ID57110
- Target namePLAAT1
- Target descriptionphospholipase A and acyltransferase 1
- Target synonymsA-C1, H-REV107, HRASLS, HRASLS1, HRSL1, HSD28, PLA/AT1, PLAAT-1, phospholipase A and acyltransferase 1, H-REV107 protein-related protein, HRAS like suppressor, HRAS-like suppressor 1, phospholipase A/acyltransferase 1, phospholipid-metabolizing enzyme A-C1
- HostRabbit
- IsotypeIgG
- Storage Instruction-20°C or -80°C,2°C to 8°C
- UNSPSC12352203